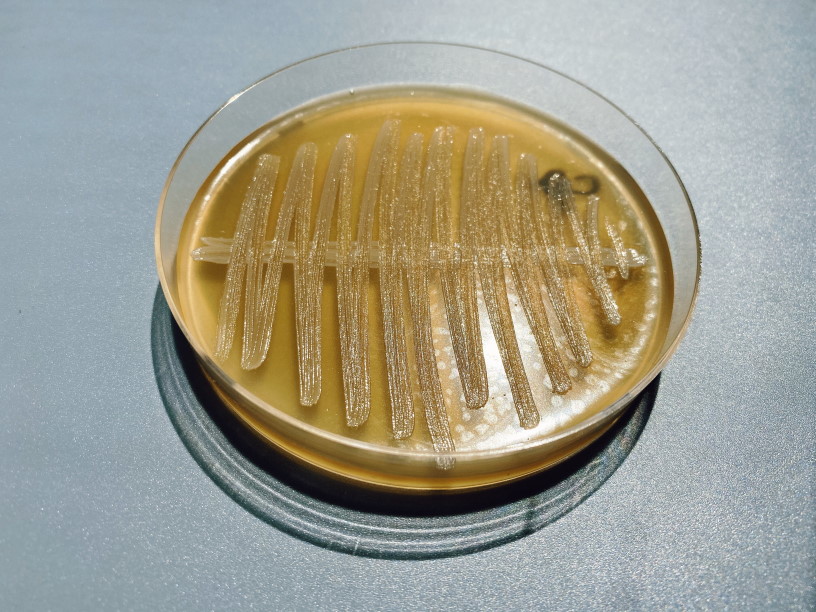

Промикробы: Крепкий орешек
Как ни крути, как ни старайся, а оказание медицинской помощи всегда сопряжено с риском получения не только этой самой помощи, но и вреда. И я сейчас не про хирурга, путающего право и лево и ампутирующего не ту ногу. Я про нозокомиальные инфекции, то есть инфекции, связанные с оказанием медицинской помощи: когда пациент долго находится на стационарном лечении, а ещё хуже — если длительное время он в реанимации, его организм ослаблен, а микрофлора, которая могла бы защитить, убита гигантскими дозами антибиотиков. Вот он и становится лакомой добычей для хищных бактерий, которые прошли через огонь, воду, медные трубы, антисептики и ультрафиолет. Избавиться от такого непрошеного гостя — задача не из лёгких.
⠀
Одним из таких маленьких злодеев является Stenotrophomonas maltophilia. Его доля в статистике внутрибольничных инфекций не так уж велика, но зато он часто обладает множественной лекарственной устойчивостью, что повышает летальность по сравнению с иными микроорганизмами.
⠀
Stenotrophomonas maltophilia — это Санкт-Петербург в микробном мире, так как этот микроорганизм сменил множество названий, а ведь впервые он был обнаружен относительно недавно — в 1943 году. Стенотрофомонасом он стал в свои пятьдесят лет — юбилей. Имечко вычурное, но объяснимое. Stenos — «узкий», как и в «стенокардии» или в «стенозе митрального клапана», а malt — «солод». Корни trophos и philos в переводе не нуждаются, я думаю. Название отражает ограниченную способность вида использовать питательные субстраты при способности образовывать кислые продукты из мальтозы («солодовый сахар»), что было использовано при разработке среды для селекции S. maltophilia.
⠀
Stenotrophomonas maltophilia — прямые палочки, подвижные за счет жгутиков. Микроорганизм широко распространен в окружающей среде — в почве, в сточных водах, на растениях. Но гораздо важнее его стремление поселиться в аппаратах искусственной вентиляции лёгких, сосудистых или мочевых катетерах. Кроме того, S. maltophilia способна к образованию микробных биопленок, что жутко усложняет их выселение.
⠀
Напомню, что биоплёнки — очень мощный и хитрый инструмент. Это несколько слоев микробных клеток, покрытых общим гликокаликсом — полимером полисахаридной природы. Большинство клеток в биопленке находится в состоянии покоя и характеризуется крайне низкой чувствительностью к воздействию антибиотиков (снижена в 100–1000 раз), антисептиков и дезинфицирующих средств, повышением устойчивости к влиянию иммунной системы и других факторов макроорганизма. S. maltophilia достаточно устойчива к факторам внешней среды. Описаны факты сохранения данного возбудителя в антисептике, содержащем хлоргексидин с цетримидом, в растворе фурацилина, в дезинфицирующих средствах. Микроорганизм способен не только сохраняться в дезинфицирующих растворах, но и расщеплять их, например фенол. Устойчивость к факторам внешней среды увеличивается при образовании биопленки.
⠀
Не каждая колония Stenotrophomonas имеет одинаковое значение: если они высеваются из образцов мочи либо из респираторного тракта, то это не всегда повод для паники или лечения. А вот появление колоний этого микробика в посевах теоретически стерильных материалов, таких как кровь, — это уже серьезно. У людей, чей иммунитет работает без перерыва и выходных, S. maltophilia является относительно редкой причиной пневмонии, инфекции мочевыводящих путей или инфекции кровотока. Однако у пациентов с ослабленным иммунитетом этот малыш гораздо чаще становится причиной легочных инфекций. А ещё S. maltophilia усложняет и так нелегкую жизнь пациентам с муковисцидозом.